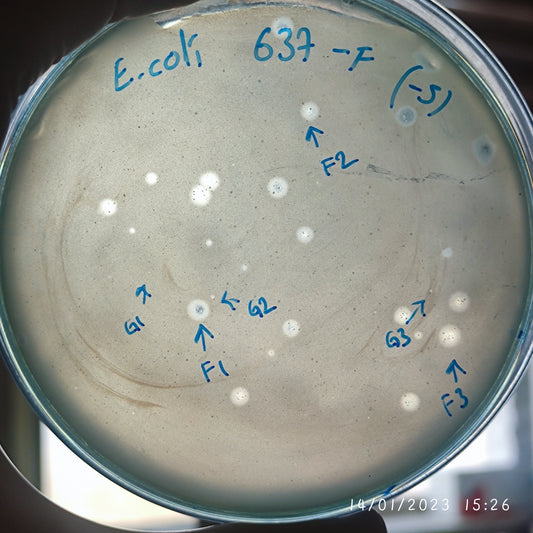
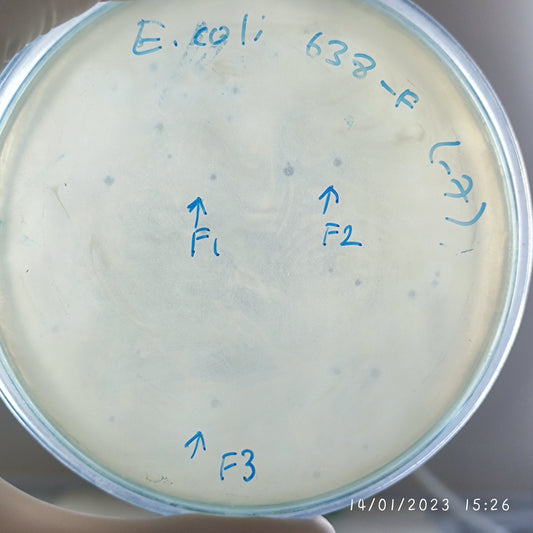
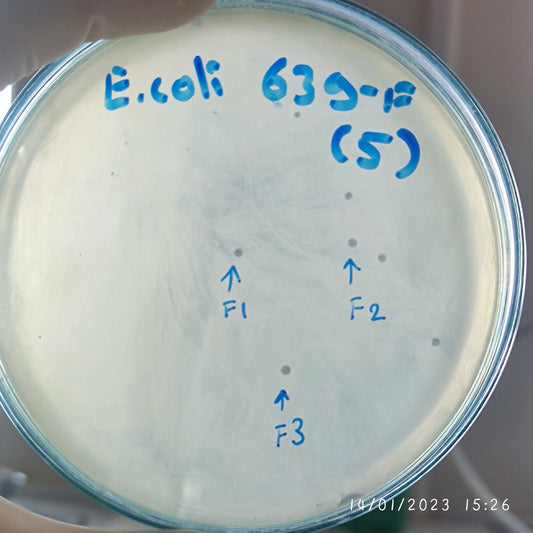
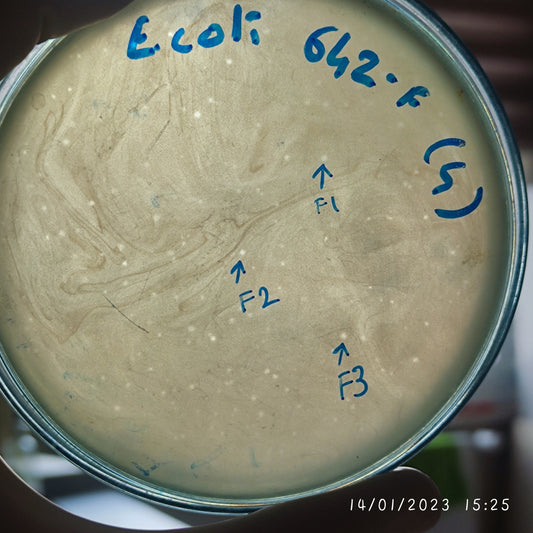
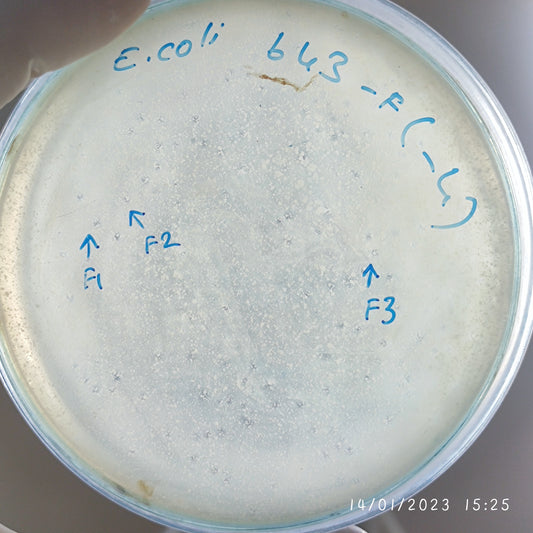
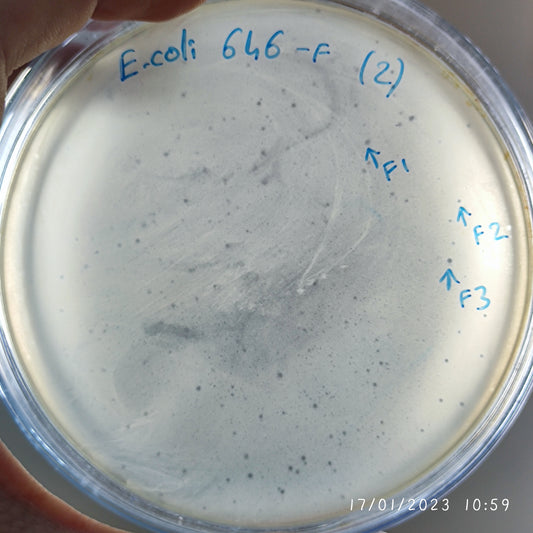
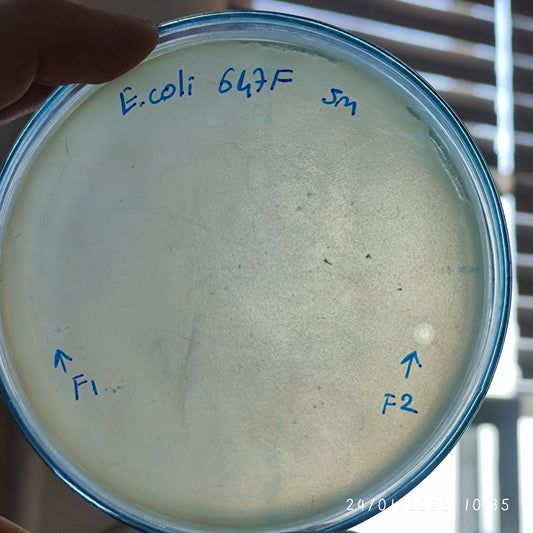
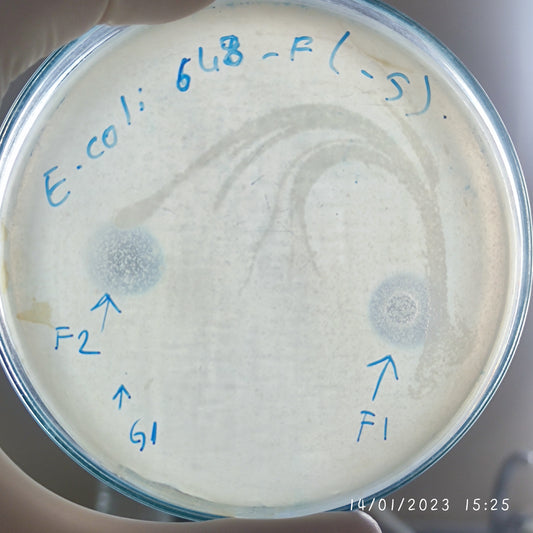
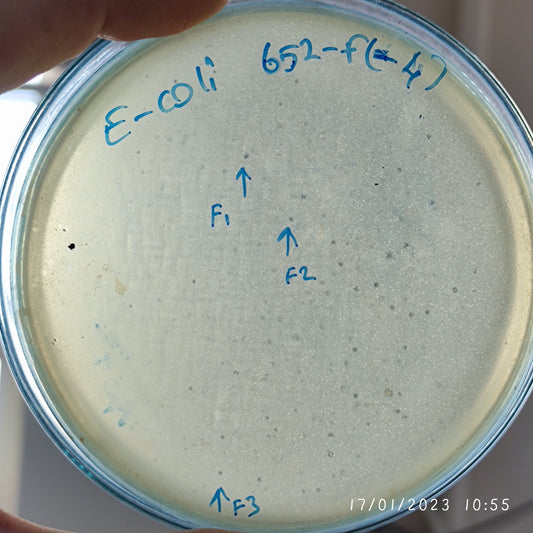
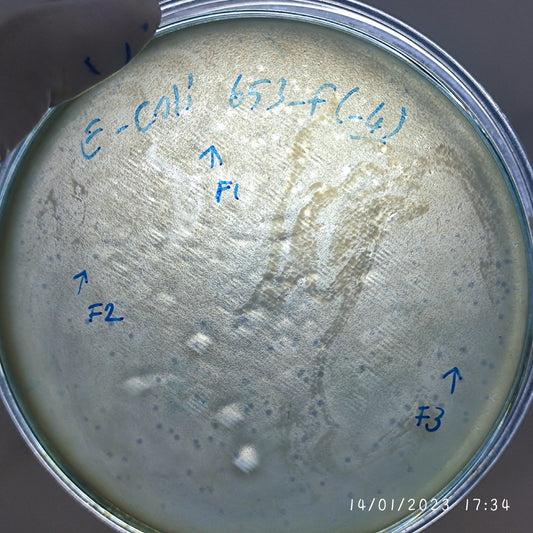
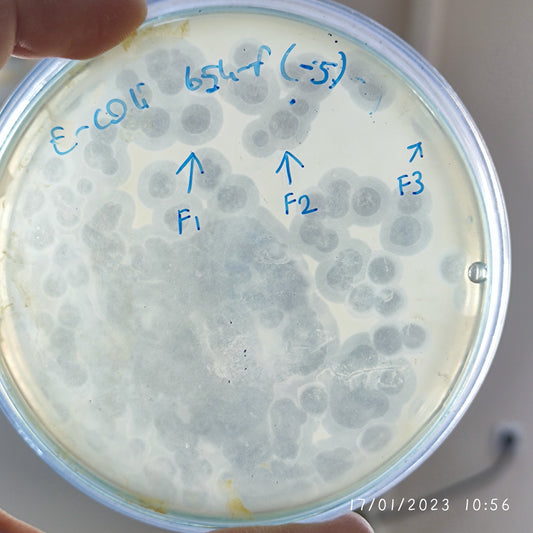
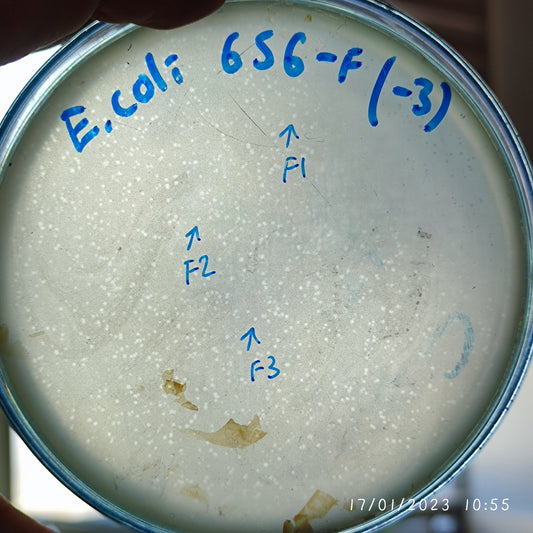

-
Escherichia coli bacteriophage 100637F
Regular price $500.00 USDRegular priceUnit price per -
Escherichia coli bacteriophage 100637G
Regular price $600.00 USDRegular priceUnit price per -
Escherichia coli bacteriophage 100638F
Regular price $500.00 USDRegular priceUnit price per -
Escherichia coli bacteriophage 100639F
Regular price $500.00 USDRegular priceUnit price per -
Escherichia coli bacteriophage 100642F
Regular price $500.00 USDRegular priceUnit price per -
Escherichia coli bacteriophage 100643F
Regular price $500.00 USDRegular priceUnit price per -
Escherichia coli bacteriophage 100645F
Regular price $500.00 USDRegular priceUnit price per -
Escherichia coli bacteriophage 100646F
Regular price $500.00 USDRegular priceUnit price per -
Escherichia coli bacteriophage 100647F
Regular price $750.00 USDRegular priceUnit price per -
Escherichia coli bacteriophage 100648F
Regular price $500.00 USDRegular priceUnit price per -
Escherichia coli bacteriophage 100648G
Regular price $500.00 USDRegular priceUnit price per -
Escherichia coli bacteriophage 100650F
Regular price $500.00 USDRegular priceUnit price per -
Escherichia coli bacteriophage 100652F
Regular price $500.00 USDRegular priceUnit price per -
Escherichia coli bacteriophage 100653F
Regular price $500.00 USDRegular priceUnit price per -
Escherichia coli bacteriophage 100654F
Regular price $750.00 USDRegular priceUnit price per -
Escherichia coli bacteriophage 100656F
Regular price $500.00 USDRegular priceUnit price per